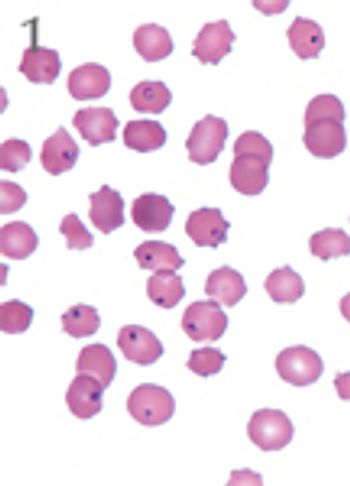
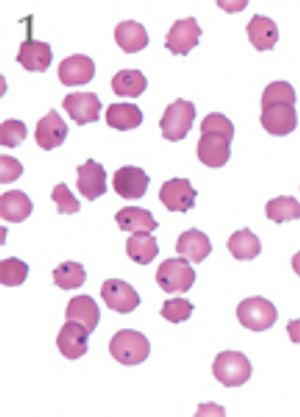

A new treatment regimen shows promise in managing cats with this serious, often fatal infection.
Department of Veterinary Medicine and Surgery
College of Veterinary Medicine
University of Missouri
Columbia, MO
A new treatment regimen shows promise in managing cats with this serious, often fatal infection.
Inhalant delivery of Aerosolized medication offers a number of theoretical benefits including an enormous absorptive surface area across a permeable membrane, a low enzyme environment that results in little drug degradation, avoidance of hepatic first-pass metabolism, and reproducible absorption kinetics.
Feline asthma is one of the most common bronchopulmonary diseases in cats and is responsible for substantial morbidity and occasional mortality. It is an IgE mediated hypersensitivity response against what otherwise would be harmless environmental Aeroallergens.
Pleural effusion is a relatively common cause of respiratory distress in the dog and cat. Both species are affected by several types of effusion, with numerous causes and variable prognosis.
Cough is a common reason for dogs to be presented for veterinary care, and tracheal collapse is a common cause of chronic cough in dogs. The tracheal lumen remains open during both inspiration and expiration thanks to the support of cartilaginous rings.
Bacterial pneumonia encompasses a wide spectrum of disease from chronic to acute, unilobar or multilobar, and with clinical signs ranging from mild tachypnea or cough to rapidly progressive and fatal pulmonary infection. Cats are subject to bacterial pneumonia far less frequently than are dogs.
Respiratory disease is common in dogs, and can result in a constellation of clinical signs. These clinical signs range from those that are irritating to owners (e.g., nasal discharge, stridorous panting, chronic hacking cough) to those which are life-threatening and require immediate medical attention.
There are several ways to obtain samples from the airways and lower respiratory tract for cytologic evaluation and microbiologic culture. In general, samples should be handled quickly since respiratory epithelial cells degrade with some rapidity after retrieval, and samples should be handled gently to avoid damaging cell membranes.
Diseases of the respiratory tract are a common reason for cats seeking veterinary medical attention. Depending on the location and type of respiratory disease, the clinical signs are variable.
Recent years have seen the emergence of previously undescribed respiratory infections in dogs and cats. Although these infections remain rare, the potential exists for substantial morbidity and mortality.
The use of inhaled respiratory medications in dogs and cats is becoming more common.
Inhalant delivery of aerosolized medication offers a number of theoretical benefits including an enormous absorptive surface area across a permeable membrane, a low enzyme environment that results in little drug degradation, avoidance of hepatic first-pass metabolism, and reproducible absorption kinetics.
Cough is a common reason for dogs to be presented for veterinary care, and tracheal collapse is a common cause of chronic cough in dogs.
Upper respiratory infections (URI) are quite common in cats. Mortality due to common URI is very rare.
Bacterial pneumonia encompasses a wide spectrum of disease, from chronic to acute, unilobar or multilobar, and with clinical signs ranging from mild tachypnea or cough to rapidly progressive and fatal pulmonary infection.
Dyspnea is the sensation of "air hunger", a somewhat anthropomorphic term for respiratory distress.
Recent years have seen the emergence of previously undescribed respiratory infections in dogs and cats.
Published: June 1st 2012 | Updated:
Published: April 1st 2010 | Updated:
Published: April 1st 2010 | Updated:
Published: April 1st 2010 | Updated:
Published: April 1st 2010 | Updated:
Published: April 1st 2010 | Updated: